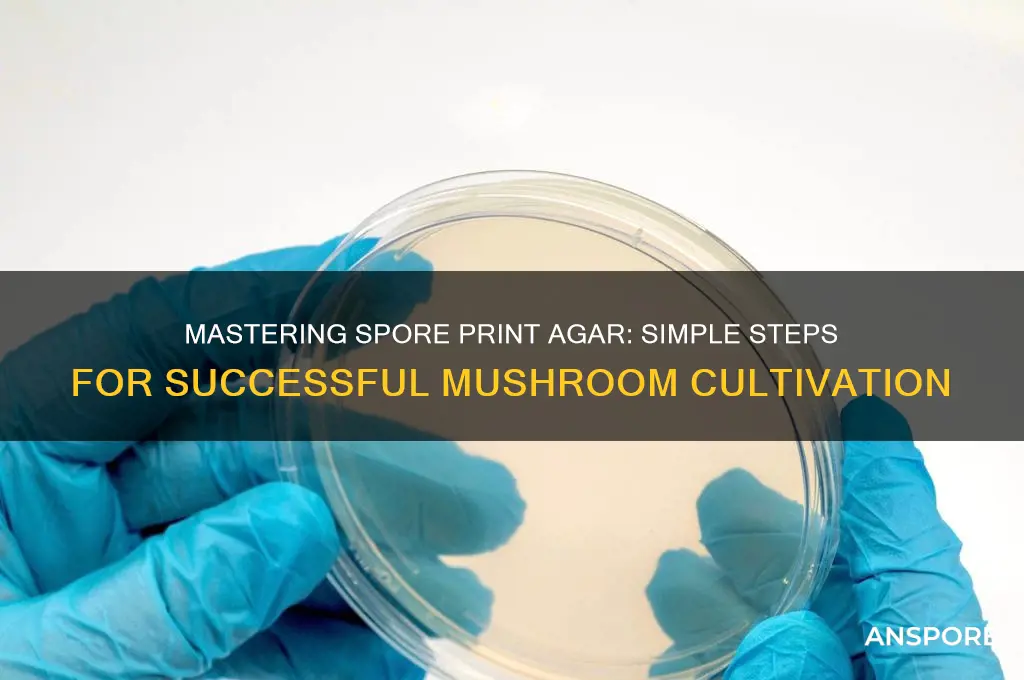
how to make spore print agar

Making spore print agar is a fundamental technique in mycology, allowing cultivators to isolate and propagate specific mushroom species from their spores. This process begins by creating a sterile agar medium, typically composed of water, agar powder, and nutrients like sugar or malt extract, which is then sterilized to prevent contamination. Once cooled, the agar is poured into Petri dishes or jars, providing a clean substrate for spore germination. To introduce spores, a spore print—made by placing the mushroom cap gills-down on a piece of foil or paper—is carefully transferred onto the agar surface using a sterile tool. The dishes are then sealed and incubated in a controlled environment, where the spores develop into mycelium, the vegetative part of the fungus. This method ensures genetic purity and is essential for both scientific research and mushroom cultivation.
| Characteristics | Values |
|---|---|
| Purpose | To create a nutrient-rich medium for isolating and cultivating mushroom spores from a spore print. |
| Base Ingredient | Agar (typically powdered agar, such as bacteriological agar or agar-agar) |
| Nutrient Source | Light malt extract, dextrose (glucose), or other simple sugars; sometimes yeast extract or peptone is added. |
| Water | Distilled or sterilized water to prevent contamination. |
| pH Level | Typically adjusted to 5.6-6.0 using a buffer solution (e.g., phosphate buffer). |
| Sterilization Method | Autoclaving at 121°C (250°F) for 15-30 minutes to ensure sterility. |
| Container | Sterile Petri dishes or jars with lids. |
| Cooling | Allow agar to cool to 50-55°C (122-131°F) before pouring into containers to prevent container damage. |
| Spore Application | Place a spore print directly onto the agar surface or use a sterile tool to transfer spores. |
| Incubation | Store in a clean, dark environment at room temperature (20-25°C or 68-77°F) for colonization. |
| Contamination Prevention | Work in a sterile environment (e.g., still air box or laminar flow hood) and use sterile techniques. |
| Storage | Prepared agar plates can be stored at 4°C (39°F) for up to 2 weeks before use. |
| Common Variations | MEA (Malt Extract Agar), PDA (Potato Dextrose Agar), or modified recipes with additional nutrients. |
| Success Indicators | Mycelium growth from spores within 7-14 days, depending on the mushroom species. |
| Troubleshooting | Contamination: Discard and sterilize equipment. No growth: Check spore viability or adjust agar recipe. |
What You'll Learn
- Sterilize Equipment: Autoclave jars, lids, and tools to ensure a sterile environment for spore growth
- Prepare Agar Solution: Mix agar powder with water, boil, and cool to create a gel medium
- Inoculate with Spores: Use a sterile syringe to inject spore solution into the cooled agar
- Incubate Properly: Store agar in a dark, warm place (70-75°F) for 7-14 days
- Monitor for Contamination: Regularly check for mold or bacteria, discarding if contamination occurs

Sterilize Equipment: Autoclave jars, lids, and tools to ensure a sterile environment for spore growth
Autoclaving is the gold standard for sterilizing equipment in mycology, leveraging high-pressure steam to eliminate contaminants that could compromise spore viability. This process is not optional—it’s the cornerstone of creating a sterile environment where spores can thrive without competition from bacteria, mold, or other fungi. Jars, lids, and tools must withstand temperatures of 121°C (250°F) for at least 15 minutes at 15 psi, ensuring all microorganisms, including their resilient spores, are destroyed. Without this step, even the most meticulously prepared agar will fail, overrun by contaminants that outcompete your target spores.
To autoclave effectively, begin by assembling your equipment: glass jars with lids, metal tools, and any other heat-resistant materials. Avoid using plastic unless it’s specifically autoclave-safe, as it can warp or melt. Loosely tighten jar lids to allow steam penetration during the cycle; fully sealed containers will not sterilize properly. Wrap tools in aluminum foil or place them in a metal tray to prevent them from rattling or damaging the autoclave chamber. Pre-cleaning all items with soap and water removes debris, ensuring the autoclave’s steam can penetrate surfaces thoroughly.
The autoclave cycle itself is precise and unforgiving. Load the chamber carefully, ensuring items are spaced to allow steam circulation. Run the autoclave for 30–45 minutes at 121°C (250°F) and 15 psi, followed by a slow cool-down period to avoid contamination from external air. Once complete, allow the chamber to depressurize naturally—forcing it open risks introducing airborne contaminants. Sterilized items should remain sealed until use, ideally within 24 hours, to maintain sterility. If storage is necessary, keep jars and tools in a clean, dry environment, protected from dust and airborne particles.
Comparing autoclaving to alternative sterilization methods highlights its superiority. Boiling water, for instance, only reaches 100°C (212°F), insufficient to kill bacterial and fungal spores. Chemical sterilants like bleach or alcohol are inconsistent and may leave residues harmful to spore growth. Pressure cookers, while similar to autoclaves, often lack the precision and temperature control required for reliable sterilization. For spore print agar, where sterility is non-negotiable, the autoclave’s consistency and thoroughness make it the only viable choice.
In practice, autoclaving requires attention to detail and safety. Always wear heat-resistant gloves when handling sterilized items, as they remain extremely hot post-cycle. Inspect jars for cracks or chips before use, as compromised glass can introduce contaminants. For home cultivators without access to an autoclave, renting time at a local lab or university may be a practical solution. While the initial setup or cost may seem daunting, the success rate of sterile cultures justifies the investment, ensuring your spore print agar remains uncontaminated and ready for inoculation.
Mastering Spore Char: Essential Tips for Perfect Smoky Flavor
You may want to see also

Prepare Agar Solution: Mix agar powder with water, boil, and cool to create a gel medium
Agar, derived from seaweed, is the backbone of spore print agar, providing a solid yet nutrient-rich surface for fungal growth. Its unique ability to gel at relatively low concentrations (typically 1.5-2% by weight) makes it ideal for this purpose. This section dissects the critical process of preparing the agar solution, a step that demands precision to ensure optimal fungal colonization.
Agar preparation begins with a simple mixture: combine 20 grams of agar powder with 1 liter of distilled water in a heat-resistant container. Distilled water is crucial to avoid contaminants that could interfere with fungal growth. Stir the mixture thoroughly to prevent clumping, ensuring a homogeneous solution. This initial step sets the foundation for a successful gel medium.
The next phase requires heat. Place the agar-water mixture on a stove and bring it to a rolling boil. Maintain this boil for approximately 5-7 minutes, stirring occasionally to prevent the agar from sticking to the bottom of the container. This boiling process hydrates the agar fully and sterilizes the solution, eliminating potential competitors to the fungal spores.
In contrast to the vigorous boiling, the cooling phase demands patience. Allow the agar solution to cool to a temperature safe for handling, ideally around 50-60°C (122-140°F). Pouring the solution too hot can damage the spores, while pouring it too cool will result in uneven gel formation. This delicate balance is crucial for creating a suitable environment for spore germination.
Once cooled, the agar solution is ready to be combined with the spore print. This gel medium provides the necessary structure and nutrients for the spores to develop into visible colonies, allowing for identification and further study. Mastering the art of agar preparation is a fundamental skill for any mycologist or enthusiast venturing into the fascinating world of fungal cultivation.
Discovering Adventures in Spore: Tips for Exploring the Game's Universe
You may want to see also

Inoculate with Spores: Use a sterile syringe to inject spore solution into the cooled agar
A critical step in cultivating mycelium from spore prints is the precise introduction of spores into a nutrient-rich agar substrate. This process, known as inoculation, requires a sterile environment and careful technique to ensure contamination-free growth. Using a sterile syringe to inject a spore solution into cooled agar is a widely adopted method, favored for its simplicity and effectiveness in distributing spores evenly throughout the medium.
Technique and Precision:
Begin by preparing a spore solution, typically 1–2 cc of sterile water mixed with spores scraped from a print. Draw this solution into a 10–20 cc sterile syringe, ensuring no air bubbles remain. Once the agar has cooled to around 100–120°F (43–49°C) but remains liquid, carefully insert the syringe needle through the self-healing injection port or a small hole in the agar container. Inject 1–2 cc of the spore solution per 1000 ml of agar, distributing it evenly to promote uniform colonization. Avoid over-injecting, as this can disrupt the agar’s structure and introduce contaminants.
Sterility and Contamination Prevention:
Sterility is paramount during inoculation. Flame-sterilize the syringe needle before and after use by passing it through a bunsen burner’s flame until it glows red. Work in a still air box or laminar flow hood to minimize airborne contaminants. If these tools are unavailable, perform the procedure in a clean, draft-free area and use a flame source to create a sterile field around the injection site. Always handle the agar and syringe with gloved hands to prevent bacterial or fungal contamination from skin contact.
Comparative Advantages:
Compared to surface inoculation methods, such as placing spore prints directly on agar, syringe injection offers greater control over spore distribution and depth. This method ensures spores are embedded within the agar, reducing the risk of surface drying or uneven growth. It is particularly advantageous for species with slow germination rates or when working with limited spore material, as it maximizes the utilization of every spore.
Practical Tips and Troubleshooting:
If the agar solidifies before injection, gently warm it to restore liquidity, but avoid overheating, which can denature nutrients. For novice cultivators, practice injecting into a test medium like water or gelatin to refine technique. If contamination occurs despite sterile procedures, re-evaluate your workspace and tools for hidden sources of contamination, such as unsterilized surfaces or improper glove handling. With patience and precision, syringe inoculation becomes a reliable method for transforming spore prints into thriving mycelial cultures.
Tea Tree Oil's Power: Can It Effectively Kill Mold Spores?
You may want to see also

Incubate Properly: Store agar in a dark, warm place (70-75°F) for 7-14 days
After the agar plates have been inoculated with spores, the incubation phase becomes critical for successful mycelial growth. Proper incubation ensures that the spores germinate and colonize the agar effectively, setting the stage for healthy cultures. The ideal environment for this process is a dark, warm space with temperatures maintained between 70°F and 75°F. This temperature range mimics the natural conditions fungi thrive in, promoting optimal growth without stressing the mycelium. Light exposure can inhibit growth or cause uneven development, so storing the plates in complete darkness is essential.
The duration of incubation varies but typically spans 7 to 14 days. This timeframe allows the mycelium to spread across the agar surface without overrunning it, which can lead to contamination risks. Patience is key; rushing the process by increasing temperatures or reducing incubation time often results in weak or incomplete colonization. Conversely, extending incubation beyond 14 days may invite contaminants or cause the mycelium to deplete nutrients prematurely. Monitoring the plates during this period is minimal—disturbing them can introduce contaminants, so resist the urge to check progress frequently.
Practical tips for maintaining the ideal incubation environment include using a dedicated incubator or a warm, draft-free area like a heating mat or the top of a refrigerator. If using a heating mat, ensure it’s set to a low, consistent temperature to avoid hot spots. For those without specialized equipment, a cardboard box lined with a towel and placed near a heat source can suffice, though temperature regulation becomes more challenging. A thermometer placed inside the incubation area helps verify that the temperature remains within the 70-75°F range.
Comparing this method to alternative approaches highlights its simplicity and effectiveness. While some cultivators use higher temperatures to expedite growth, this often sacrifices mycelial health. Others attempt to incubate in ambient room conditions, but fluctuations in temperature and light exposure frequently lead to failure. The dark, warm incubation method strikes a balance, prioritizing mycelial vigor over speed. It’s a technique favored by both beginners and experienced cultivators for its reliability and minimal equipment requirements.
In conclusion, proper incubation is a cornerstone of successful spore print agar preparation. By maintaining a dark, warm environment within the specified temperature range for 7 to 14 days, cultivators create conditions that foster robust mycelial growth. This phase demands patience and precision but rewards with healthy, viable cultures ready for the next steps in cultivation. Master this step, and the rest of the process becomes significantly more straightforward.
Removing Drywall: Risks of Spreading Mold Spores and Prevention Tips
You may want to see also

Monitor for Contamination: Regularly check for mold or bacteria, discarding if contamination occurs
Contamination is the arch-nemesis of any successful spore print agar project. Even a single speck of mold or bacteria can derail weeks of careful cultivation, rendering your agar useless. Vigilance is key. Regularly inspect your agar plates for any signs of unwanted growth, especially during the critical incubation period. Look for discoloration, fuzzy patches, or unusual textures that deviate from the expected appearance of your target fungi.
Early detection is crucial. Catching contamination in its infancy allows you to discard the affected plate before the invaders spread to other containers or compromise your entire setup. Remember, it's better to sacrifice one plate than risk losing your entire batch.
Think of your agar plates as miniature ecosystems. Just like any ecosystem, they are susceptible to invasion by foreign organisms. Mold spores and bacteria are ubiquitous in the environment, constantly seeking new habitats. Your agar, rich in nutrients, provides the perfect breeding ground. By maintaining a sterile environment and practicing good laboratory techniques, you can significantly reduce the risk of contamination. This includes using sterile tools, working in a clean area, and avoiding unnecessary exposure of your plates to the open air.
Consider using a laminar flow hood if available, as it provides a sterile workspace with filtered air, minimizing the introduction of airborne contaminants.
Don't be discouraged if contamination occurs. It's a common challenge in mycology and often a learning experience. Analyze the situation: was it due to a lapse in sterile technique, improper sealing of containers, or perhaps an issue with the agar preparation itself? Identifying the source of contamination allows you to implement corrective measures and improve your success rate in future attempts. Remember, even experienced cultivators encounter setbacks. The key is to learn from them and refine your process.
Transform Your Spore Creature: A Step-by-Step Character Customization Guide
You may want to see also
Frequently asked questions
Spore print agar is used to capture and cultivate fungal spores for identification, study, or cultivation. It provides a sterile medium for spores to germinate and grow into mycelium.
You will need agar powder, distilled water, a pressure cooker or autoclave for sterilization, petri dishes, a spore print, and a sterile workspace or laminar flow hood to prevent contamination.
Once the agar has cooled and solidified in the petri dish, gently press the spore print onto the surface of the agar using sterile technique. Alternatively, use a sterile tool to scrape spores from the print and sprinkle them onto the agar. Seal the dish and incubate in a controlled environment.







